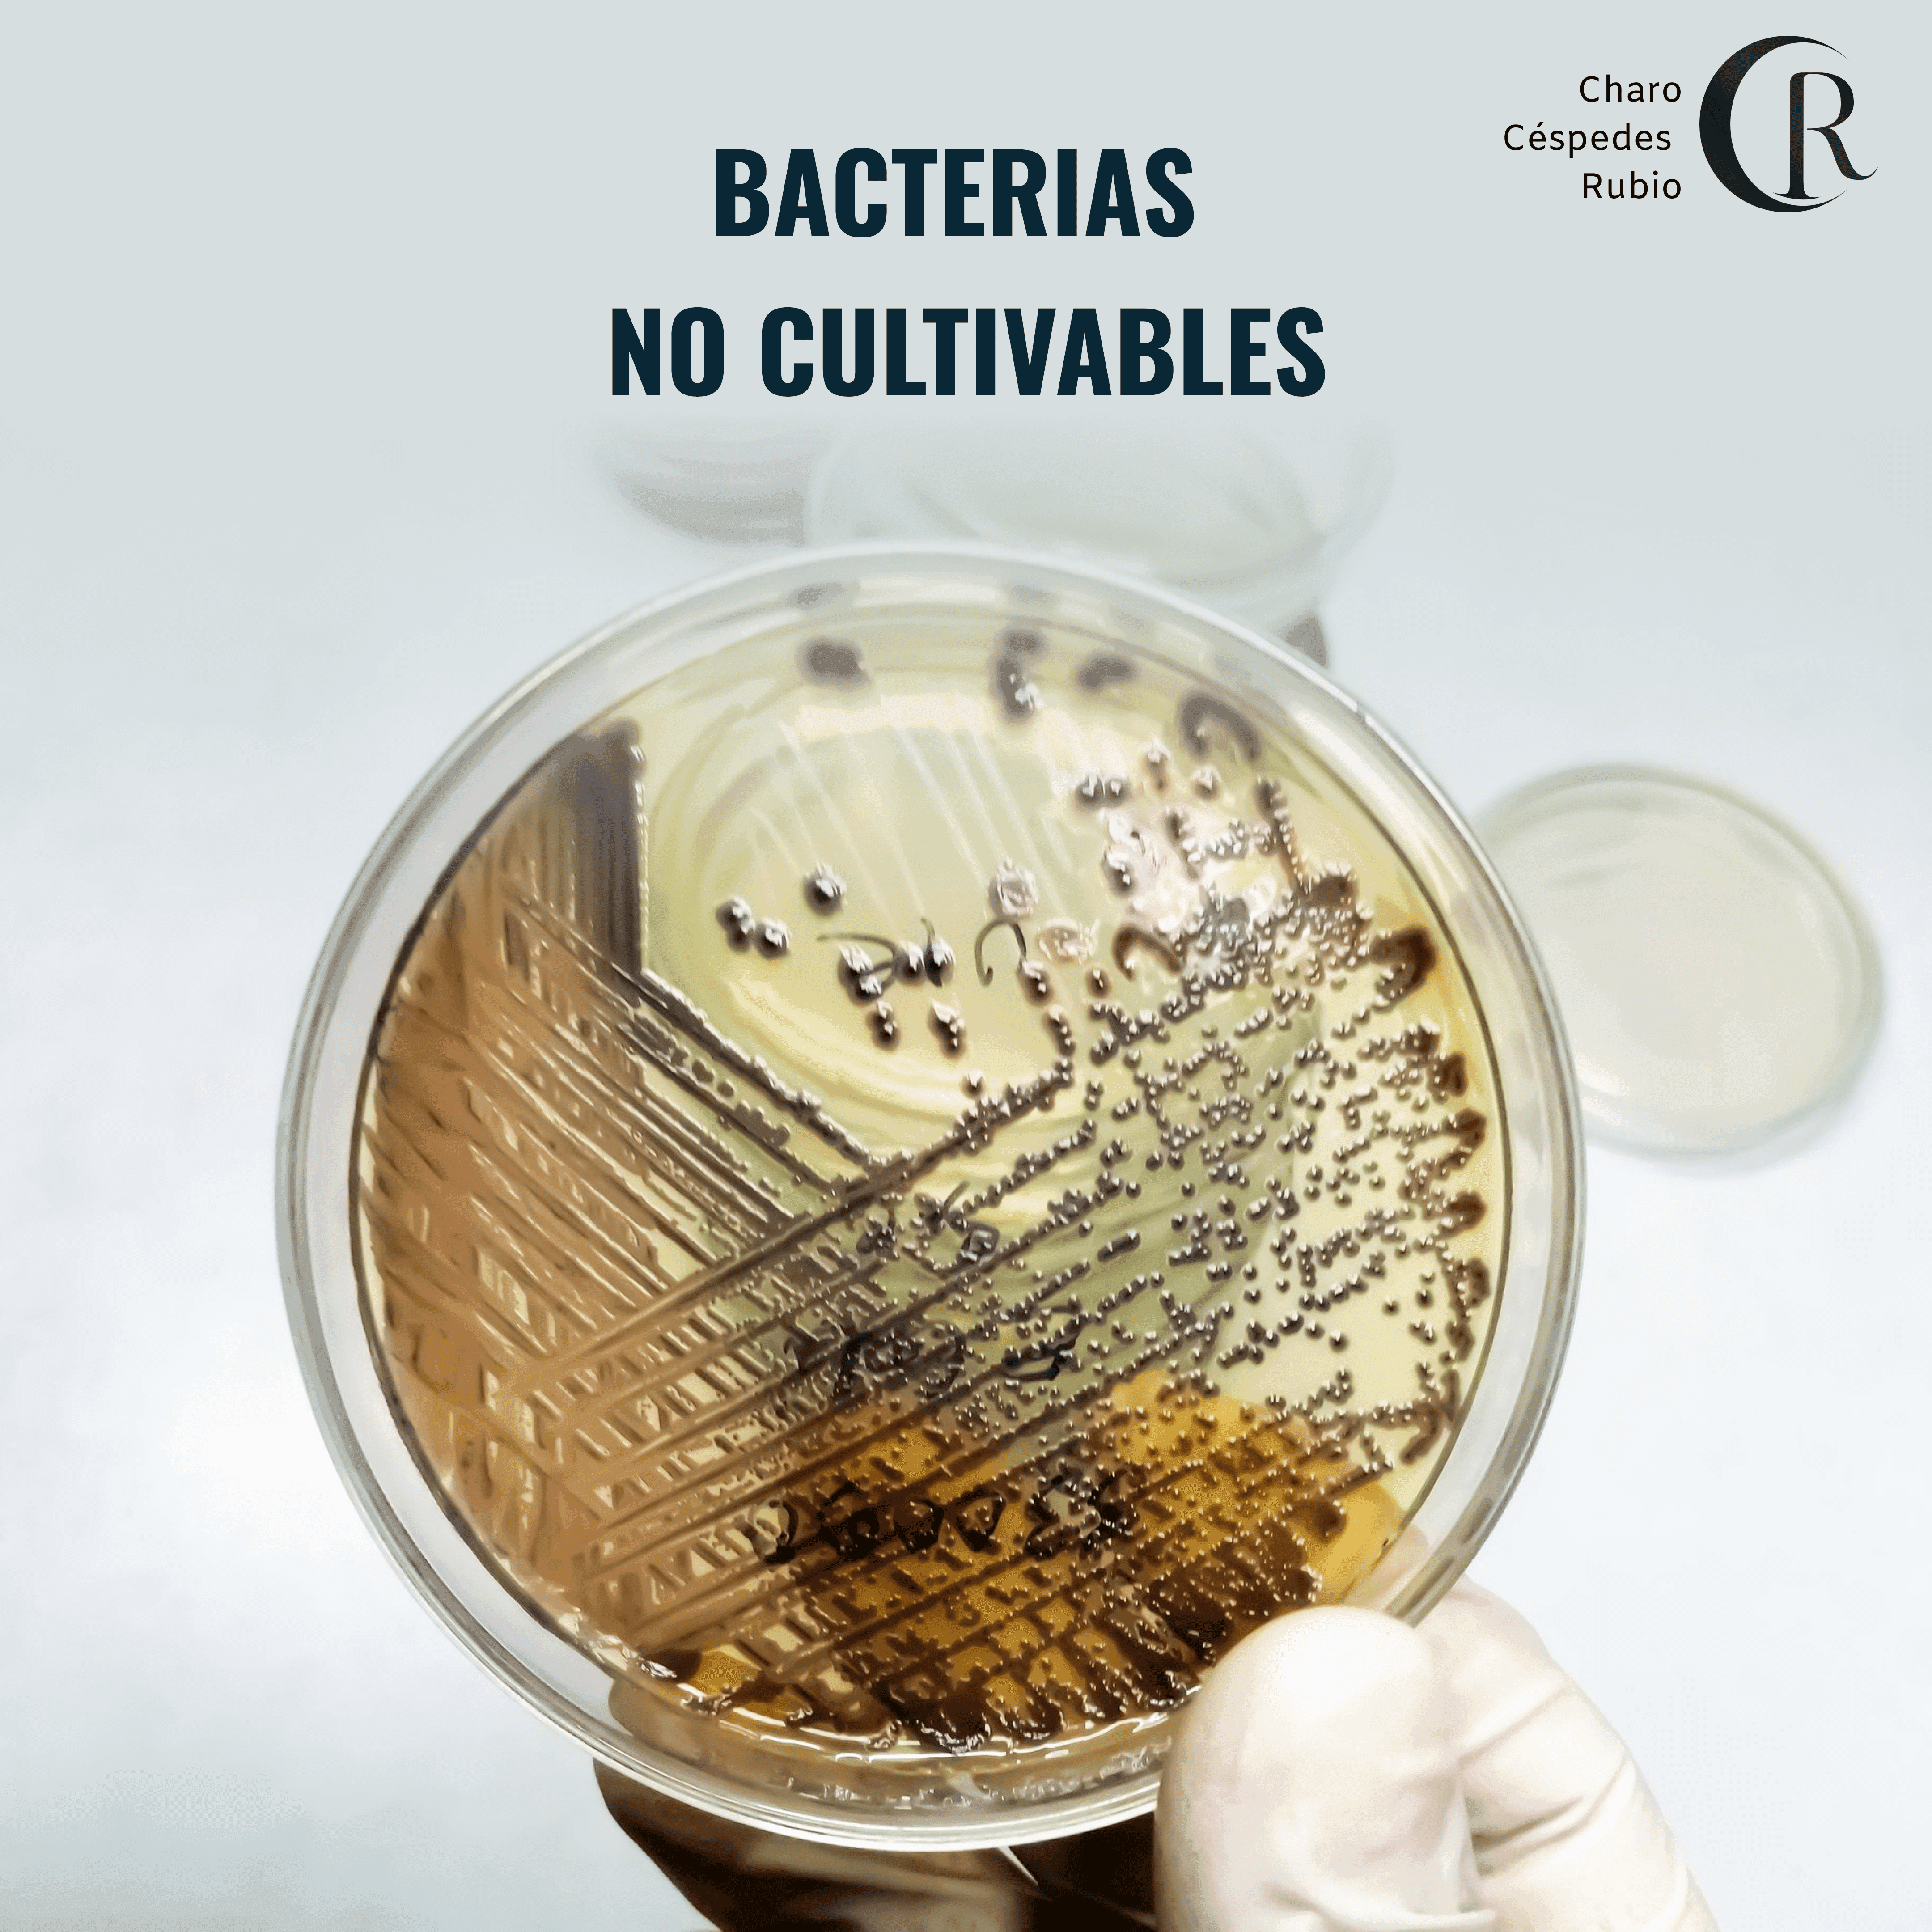

Microbiología
Cómo cultivar "bacterias no cultivables"

Charo Céspedes Rubio
Biología | Bacteriología y Laboratorio Clínico | Microbiología Clínica
8 ago 2024
¿Sabes que existen muchas bacterias que no crecen en los medios de cultivos tradicionales?
Robert Koch fue el primero en cultivar bacterias en medios sólidos y tras varias modificaciones, ya llevamos más de 120 años usando el agar para la preparación de los medios de cultivo.
Sin embargo, muchos microorganismos no crecen en estos medios y no los podemos cultivar.
Gracias a estudios realizados por un grupo de investigadores japoneses, se descubrió que cuando se autoclavan juntos el fosfato y el agar para preparar un medio sólido, la cantidad de colonias bacterianas obtenidas se reduce a la mitad a diferencia de cuando se autoclavan de forma separada.
Esto se debe a que al estar juntos el agar y el fosfato se generan compuestos tóxicos que inhiben el crecimiento bacteriano (peróxido de hidrógeno).
Según la OMS, anualmente 600 millones de personas enferman y 420.000 mueren por el consumo de alimentos contaminados. Parte de estas cifras están relacionadas con la habilidad bacteriana para sobrevivir en ambientes estresantes, entrando en el estado viable pero no cultivable (VBNC), en el que no son detectadas por métodos convencionales.
Estos microorganismos afectan a diferentes sectores causando pérdidas económicas directas e indirectas y afectando a la salud de personas y animales.
Así se confirma la idea de que la mayoría de los microorganismos ambientales no son cultivables en los medios convencionales, lo que ha impulsado a buscar nuevas alternativas.
Para esto, se estudia cambiar la composición de los medios o las condiciones de cultivo, utilizando estrategias como cultivos in situ:
Cámaras de difusión:
Son dispositivos que se colocan en un entorno determinado, como suelo (tierra) o sedimentos marinos.
Contiene un agar donde se inoculan microorganismos de dicho entorno
Y unas membranas con un tamaño de poro muy pequeño (0,03 micras)
De esta manera los microorganismos del agar no pueden salir de la cámara y los del entorno no pueden entrar en ella. Sólo los nutrientes, que son moléculas pequeñas, pueden atravesar los poros y llegar hasta el agar.
Trampas microbianas:
Son dispositivos similares a las cámaras de difusión que se colocan en el suelo, pero se diferencian en dos aspectos:
El agar no está inicialmente inoculado con microorganismos
La membrana inferior tiene poros más grandes (0,2 micras) que permiten que los actinomicetos entren y crezcan en el agar
Estas técnicas abren camino al cultivo de nuevos microorganismos y por tanto al descubrimiento de nuevas moléculas con propiedades interesantes como antibióticos.